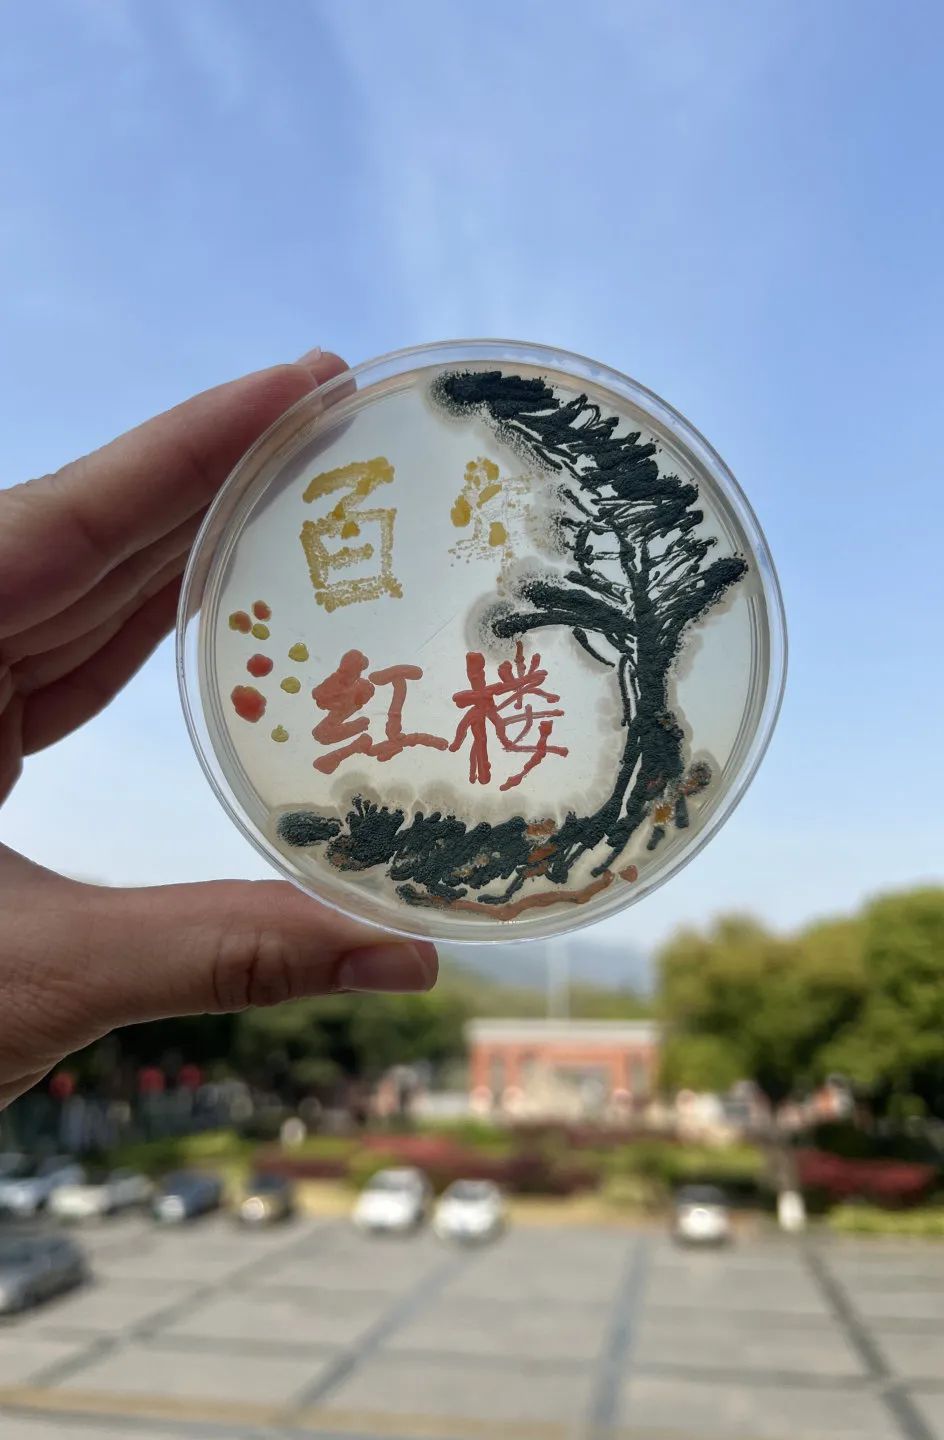
图片

“求进”视线 | 省级内涵建设项目+1!打造科学教育“无锡样板”
近日
2025年江苏省基础教育内涵建设项目
名单揭晓
无锡市第一中学与无锡市教育科学学院
联合申报的
《“四维融合”大科学育人体系建设
——基于无锡一中科学教育特色高中的创新实践》
项目脱颖而出
并立项为“基础教育综合改革重点工作”
这标志着
我校在探索科学教育特色发展的道路上
将树立起新的标杆


百年传承,科学教育厚植创新沃土
无锡一中自1911年建校,114载栉风沐雨,始终将自身发展融入民族复兴洪流。学校以“独立、协作、创造”为训,以“读书、明理、求进”为风,矢志培育兼具创新能力与终身学习力的时代新人,成就了以钱伟长、姚桐斌为代表的著名科学家,走出了十位两院院士。
作为国家级示范高中与江苏省高品质高中建设学校,无锡一中科学教育底蕴深厚、特色卓然。学校以科技创新为育人内核,勇立潮头:率先探索物理实验教学创新设计、高中STEM教育基地实验项目的设计、“设计与智造”的大技术融合育人、高中学段工程教育改革等,形成了多维度融合的科学教育生态。
表1 科学教育内涵建设项目
内涵项目类别 | 内涵项目名称 |
江苏省高中课程基地 | 物理实验教学创新课程基地 |
基于STEM的数学创新人才培养课程基地 | |
像工程师一样实践:普通高中工程整合课程基地 | |
江苏省基础教育前瞻性教学改革项目 | 设计与智造:统整理念下高中生学习方式的变革 |
大模型教学:深度发展科学思维的高中理科实践研究 | |
江苏省基础教育示范性育人模式研创工程项目 | 普通高中学科融合育人模式创生行动 |
无锡市中小学内涵建设项目 | 设计与智造:指向工程素养的技术课程重构 |
表2 省市级科学教育荣誉
级别 | 名 称 |
国 家 级 | 全国中小学现代教育技术实验学校 |
全国青少年创客教育联盟理事单位 | |
全国青少年人工智能活动特色单位 | |
省 级 | 江苏省STEM教育试点学校 |
江苏省“十四五”科学教育综合示范学校 | |
江苏省首批智慧校园示范校 | |
江苏省计算机科普教育基地 | |
市 级 | 无锡市中小学工程教育重点学校 (全市共五所) |
无锡市科技教育特色学校 | |
无锡市青少年科技创新教育示范学校 | |
无锡市中小学人工智能重点学校创建立项单位 | |
无锡市青少年科技创新市长奖-创新教育摇篮奖 |
项目引领,四维融合构建育人新局
2023年2月21日,习近平总书记强调要在教育“双减”中做好科学教育加法,《教育强国建设规划纲要(2024—2035年)》提出,探索设立一批以科学教育为特色的普通高中,办好综合高中,我校积极响应,率先开启科学教育特色高中建设的探索。通过顶层设计,以课程体系为骨架、教学创新为灵魂、资源协同为脉络、师资培养为引擎,形成“全链条育人”格局。

课程筑基: “强基础,宽领域,重实践,促探究”,设置全面又具特色的主题科学课程体系,文理交叉,跨学科学习,涵养品德,提升科学素养。


教学创新: 以探究式、课题式、项目化重塑课堂,树立多层级、多维度实验教学机制,激发科学思维与实践热情;

资源协同: 创设泛在学习环境,建设“135”科技教育学习场景,逐步形成“校内深度探究+校外多元实践”的全方位育人场域。


师资驱动: 建立“科研院所-高校-企业-学校”协同培养机制,为学生配备“学科导师+行业专家”的双师团队,点燃创新引擎。
无锡一中正全力构建
“基础扎实、特色鲜明、创新活跃”的
大科学教育新格局
其“四维融合”实践
为全省乃至全国科学教育特色高中的建设
提供了可借鉴、可推广的“无锡样本”
也为百年名校的发展史册续写着新的篇章
站在新的起点上
无锡一中将继续以敢为人先的锐气
深耕科学教育沃土
为培育担当民族复兴大任的栋梁之才
为教育强国建设贡献一中智慧与力量
文字丨张月香
编辑丨王红艳
审核丨朱晴怡
发布丨鲍静










